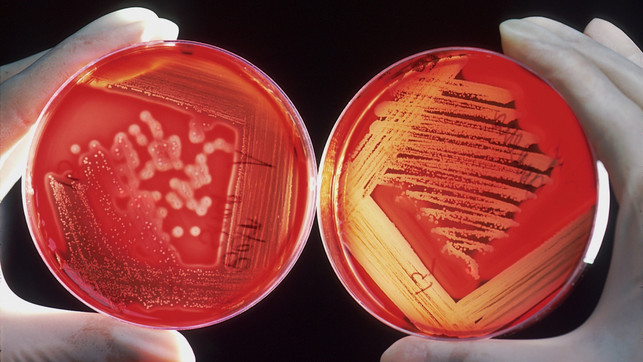
Bild 7

Sexuell übertragbare Krankheiten (sexually transmitted infections, STI) sind auch in unserer angeblich aufgeklärten Zeit noch immer ein Tabu. Man spricht nicht darüber, schon gar nicht öffentlich, zu groß ist die Scham, sich „so etwas“ eingefangen zu haben. Menschen, die an STI erkranken, werden immer noch von der Gesellschaft stigmatisiert. Dabei ist gerade die Aufklärung über sexuell übertragbare Krankheiten enorm wichtig. Wir schauen uns die Hintergründe dazu mal genauer an.
Über sexuell übertragbare Krankheiten zu reden ist wichtig, für uns selbst und auch für unsere Gesellschaft. Fast alle Geschlechtskrankheiten sind im Anfangsstadium gut zu behandeln, einige können geheilt werden. Bei den viralen STI wie HIV lässt sich ein Ausbruch der Krankheit verhindern oder der Verlauf stoppen. Das setzt aber voraus, dass wir die Symptome kennen und rechtzeitig darauf reagieren.
Aufklärung, schon von Kindern und Jugendlichen vor oder in der Pubertät, bedeutet aber nicht nur, dass Geschlechtskrankheiten frühzeitig behandelt werden können. Es bedeutet ebenso, dass ein Bewusstsein entsteht, wie man sich vor sexuell übertragbaren Krankheiten schützt. So schützen wir auch andere, indem wir verhindern, eine STI unerkannt an unsere Partner:in oder sogar unbeteiligte Dritte weiterzugeben. Denn manche dieser Krankheiten können nicht nur über sexuellen Kontakt, sondern auch bei anderen Gelegenheiten, etwa in der Sauna oder in Whirlpools übertragen werden.
Offen mit einem Thema umzugehen, trägt außerdem dazu bei, das Tabu zu brechen und die psychische Belastung von Betroffenen zu reduzieren. Je „normaler“ es ist, über STI zu reden, desto eher suchen sich Erkrankte auch Hilfe. Deswegen machen wir den Anfang und sprechen über sexuell übertragbare Krankheiten, deren Verbreitung und die Auswirkungen auf deine Gesundheit.
Aufklärung ist Vorsorge
Eine aktuelle Studie zeigte nämlich, dass die Deutschen viel zu wenig über sexuell übertragbare Krankheiten wissen. HIV und AIDS kannten dank großer Kampagnen in den 1990er Jahren immerhin mehr als 70 Prozent der Befragten. Bei Gonorrhö und Syphilis war es nur noch etwa ein Drittel. Hepatitis B und genitaler Herpes waren nur jedem Zehnten ein Begriff, bei Genitalwarzen oder Filzläusen lag der Wert sogar weit darunter.
Unbehandelt können diese Infektionen jedoch auch an anderen Stellen im Körper schwere Erkrankungen hervorrufen. Sich informieren und davor schützen ist daher aktive Gesundheitsvorsorge. Seit 2016 liefert die Aufklärungskampagne „Liebesleben“ der Bundeszentrale für gesundheitliche Aufklärung mit witzigen Bildern und Sprüchen unter anderem auf Social Media Infos rund um STI, deren Ausbreitung und Behandlungsmöglichkeiten. Und das auch abseits von HIV.
Am 1. Dezember erinnert jedes Jahr der Welt-AIDS-Tag daran, dass HIV und AIDS immer noch zu den wichtigsten STI zählen. Die Krankheit ist nach wie vor nicht heilbar, sofern rechtzeitig diagnostiziert aber gut behandelbar, sodass infizierte Personen keine Einschränkungen im Alltag haben müssen. Das funktioniert aber nur, wenn wir uns dessen bewusst sind und weiterhin öffentlich darüber gesprochen wird – genau das soll der Welt-AIDS-Tag bewirken.
Schau dazu auch: Safer Sex – Wie gut bist Du informiert?

Sexuell übertragbare Krankheiten im Überblick
Die Symptome einer sexuell übertragbaren Krankheit können vielfältig sein, etwa ein brennendes Gefühl beim Toilettengang oder Juckreiz und Ausschlag im Intimbereich. Den besten Schutz vor einer Ansteckung mit sexuell übertragbaren Krankheiten (STI) bietet die Benutzung eines Kondoms. Aber auch die gründliche Reinigung von Geschlechtsteilen und Händen vor und nach dem Sex kann hier das Risiko minimieren helfen. Und natürlich, zu wissen, welche Infektionen es gibt und wie sich diese äußern können. Deswegen haben wir die wichtigsten in unserer Übersicht zusammengefasst.
Häufige STI: Chlamydien
Chlamydien sind eine Bakterienart, die hauptsächlich auf den Schleimhäuten von Scheide, Penis und Po siedeln. Übertragen wird diese Krankheit ganz klassisch beim Geschlechtsverkehr ohne Kondom. Eine Infektion mit diesen Bakterien zählt zu den häufigsten STI und bleibt oft unbemerkt, weil sie keine oder nur sehr leichte Symptome wie Schmerzen beim Urinieren, ungewöhnlicher Ausfluss aus Scheide oder Penis oder Schmerzen beim Geschlechtsverkehr verursacht.
Die Beschwerden verschwinden zwar oft von selbst wieder, unbehandelt kann einen Chlamydieninfektion jedoch im Körper wandern und beispielsweise zur Unfruchtbarkeit führen. Auch können sich die Bakterien in den Gelenken ansiedeln und dort Entzündungen hervorrufen.

Creme und Shampoo gegen Filzläuse
Filzläuse sind winzige Insekten, die sich bevorzugt in der Schambehaarung einnisten und dort Juckreiz und Hautentzündungen hervorrufen. Die Filzläuse werden schon durch engen Körperkontakt übertragen, auch eine Rasur des Intimbereichs schützt nur bedingt vor den kleinen Plagegeistern. Diese haben zwar außer lokalen Hautirritationen keine größeren gesundheitlichen Folgen, aber blutig gekratzte Stellen erhöhen natürlich die Gefahr, sich mit anderen sexuell übertragbaren Krankheiten zu infizieren.
Die Behandlung mit Cremes und speziellen Shampoos ist gut wirksam, sollte aber auch immer zeitgleich vom Partner durchgeführt werden, damit die kleinen Parasiten nicht einfach fröhlich weiter von einem Wirt zum anderen wechseln können. Auch die Bettwäsche und Kleidung sollte bei einem Befall ausreichend desinfiziert werden.
Durch Bakterien verursacht: Gonorrhö
Gonorrhö (auch als „Tripper“ bezeichnet) wird durch Bakterien verursacht und fast ausschließlich beim Sex (egal ob vaginal, anal oder oral) übertragen. Männer sind stärker betroffen als Frauen, bei Letzteren treten oft nur kleine oder geringe Symptome auf. Allgemein kommt es unter anderem zu Brennen oder Schmerzen beim Urinieren, Schmerzen beim Sex oder Ausfluss aus Scheide, Penis oder After. Bei Männern sind oft auch Prostata und Hoden entzündet und sehr schmerzhaft geschwollen, nach Oralsex kommt es zu Halsentzündungen.
Bleibt eine Gonorrhö unbehandelt, kann sie langfristig zu Unfruchtbarkeit führen und die Wahrscheinlichkeit einer Infektion mit HIV bei ungeschütztem Sex erhöhen. Gelangen die Bakterien in die Augen, können sie zur Erblindung führen, etwa bei Babys während der Geburt.

Schutzimpfung teilweise möglich: Hepatitis
Hepatitis, egal welchen Typs, wird durch Viren verursacht, die eine Entzündung der Leber auslösen. Als STI tritt meist Hepatitis B auf, da die Viren dieser Form in allen Körperflüssigkeiten, besonders aber in Blut, Scheidensekret, Sperma und Speichel vorkommen. Hepatitis C Erreger befinden sich dagegen nur im Blut und können daher nur über den Kontakt kleinster Hautverletzungen übertragen werden, was diese Form weniger ansteckend macht. Als sexuell übertragbare Krankheit spielt sie daher kaum eine Rolle.
Hepatitis B verläuft in vielen Fällen symptomlos, sodass eine Ansteckung unbemerkt bleibt. Bricht die Krankheit aus, kommt es zu Leberentzündung mit Fieber, Gelbsucht und allgemeiner Abgeschlagenheit. Die akute Entzündung heilt meist von selbst ab, manchmal jedoch wird sie chronisch und verursacht dann bleibende Schäden an der Leber (Zirrhose).
Als Viruserkrankung ist Hepatitis B in der akuten und chronischen Form nicht behandelbar. Auch lässt sich eine Ansteckung durch Safer Sex kaum verhindern, zu weit verbreitet sind die Erreger in den Körperflüssigkeiten. Den einzig wirksamen Schutz gegen Hepatitis B bietet eine Schutzimpfung, die schon bei Kindern und Jugendlichen durchgeführt werden kann.
Weit verbreitet und bekannt: Herpes
Herpes Simplex ist eine weit verbreitete und bekannte STI. Nach der Erstinfektion kommt es immer wieder zu akuten Schüben, die schmerzhafte, nässende und hochansteckende Bläschen verursachen. Je nachdem, wo diese Bläschen auftreten, unterscheidet man zwischen Typ 1, Lippenherpes, und Typ 2, Genitalherpes.
Übertragen wird die Krankheit vornehmlich durch Kontakt mit diesen Bläschen, deswegen sollte Sex in jeder Form während eines akuten Schubes tabu sein. Ausgelöst werden die Schübe durch ein geschwächtes Immunsystem, etwa bei Stress, durch andere Infektionen oder bei Frauen auch während der Menstruation.
Gegen Herpes gibt es keine Behandlung oder Schutzimpfung, die Symptome eines Schubs können jedoch mit virushemmenden Medikamenten deutlich gelindert werden. Diese Medikamente verlängern auch die Pausen zwischen den Schüben und helfen dem Immunsystem, den Virus im Griff zu behalten.

Bekannteste sexuell übertragbare Krankheit: HIV und AIDS
HIV, das Humane Immunschwäche Virus, ist die mit Abstand bekannteste sexuell übertragbare Krankheit weltweit. Das HI-Virus reduziert die Abwehrkräfte des Körpers über die Jahre so stark, dass schließlich eigentlich harmlose Krankheiten für die Betroffenen schwerwiegende Folgen haben – sie leiden an AIDS (erworbene Immunschwäche).
Das Virus kommt hauptsächlich in den beim Sex beteiligten Körperflüssigkeiten vor, eine Ansteckung erfolgt beim Kontakt dieser Flüssigkeiten mit kleinen und kleinsten Hautverletzungen. Der beste Schutz ist daher, beim Geschlechtsverkehr aber auch beim Oralsex immer ein Kondom zu verwenden und dieses sorgfältig zu entsorgen.
HIV ist nämlich heimtückisch, eine Infektion bleibt oft unbemerkt, weil keine Symptome auftreten. Erst, wenn das Immunsystem stark beeinträchtigt ist, fällt die Erkrankung auf. Zu diesem Zeitpunkt ist eine Behandlung mit virushemmenden Medikamenten jedoch nur noch eingeschränkt wirksam. Wer vermutet, sich mit HIV angesteckt zu haben, sollte sich daher testen lassen und auch seine Partner:in darüber informieren. Früh erkannt, lässt sich die Geschlechtskrankheit zwar nicht heilen, aber die Medikamente können den Ausbruch der Krankheit verhindern.
Häufigste sexuell übertragbare Viruskrankheit: HPV und Feigwarzen
HPV, das Humane Papilloma Virus, ist vermutlich die häufigste sexuell übertragbare Viruskrankheit. Typische Symptome sind die sogenannten „Feigwarzen“ im Genitalbereich. Ein Großteil der über 100 bekannten Virusarten ist harmlos, ein paar jedoch lösen Veränderungen im Gewebe aus, die unter anderem Gebärmutterhalskrebs verursachen können. Schutz gegen diesen schweren Verlauf der Erkrankung bietet seit einigen Jahren eine Impfung gegen HPV.

Kein vollständiger Schutz: Syphilis
Syphilis ist eine durch Bakterien verursachte STI, die in drei Phasen verläuft. In der ersten Phase treten typischerweise kleine, harte Knötchen im Genitalbereich auf, die zu Geschwüren werden und dann abheilen. In der zweiten Phase kommt es zu juckenden, teilweise nässenden Ausschlägen am Körper, die abheilen und wieder auftreten. Dazu kommen Fieber, Schmerzen in Muskeln und Gelenken, Appetitlosigkeit und geschwollene Lymphknoten. In der dritten Phase haben die Erreger den gesamten Körper befallen und verursachen überall Entzündungen und harte, gummiartige Knoten, die zu schweren Organschäden führen können.
Die einzelnen Phasen verlaufen oft mild und es liegen Monate oder sogar Jahre dazwischen, deswegen bleibt eine Syphilis anfangs meist unbemerkt. Dennoch ist es wichtig, sich bei einem Verdacht frühzeitig auf die Bakterien testen zu lassen. Die Antibiotika können zwar die Syphilis beseitigen, Schäden an Organen lassen sich damit jedoch nicht reparieren.
Einen vollständigen Schutz gegen Syphilis gibt es übrigens nicht, ein Kondom kann das Risiko jedoch erheblich mindern. Auch sollte bei einer bekannte Syphilis-Infektion auf Sexualkontakte verzichtet werden, da die Krankheit sehr ansteckend ist.
Sexuell übertragbare Krankheit: Trichomonaden
Trichomonaden sind Einzeller, die sich in den Schleimhäuten ansiedeln und dort Entzündungen verursachen. Obwohl die Infektion sehr häufig auftritt, bleibt sie oft unbemerkt, da Männer wenig bis keine Symptome zeigen. Bei Frauen kommt es zu Ausfluss aus der Scheide, brennen und Schmerzen beim Urinieren und Schmerzen beim Geschlechtsverkehr.
Schutz vor der Ansteckung bietet, wie bei fast allen STI, die Benutzung eines Kondoms. Trichomonaden sind gut behandelbar, meist gibt es Tabletten, deren Wirkstoff die Einzeller abtötet und damit auch die Symptome verschwinden lässt.
Lies dazu auch: Gelassenheit lernen: Dein Weg zu seelischer Gesundheit
Was tun bei Geschlechtskrankheiten?
Sexuell übertragbare Krankheiten sind ein sehr sensibles und persönliches Thema, das viel mit Scham verbunden ist. Betroffene lassen sich nicht untersuchen, obwohl sie eine STI vermuten. Dabei gibt es etliche Möglichkeiten, an eine Behandlung zu kommen.
Erste Anlaufstelle bei Verdacht auf eine Geschlechtskrankheit ist der Hausarzt des Vertrauens, aber auch Hautärzte, Frauenärzte oder Urologen können hier weiterhelfen. Der Arzt führt Untersuchungen durch und nimmt Proben (beispielsweise Blutproben oder Abstriche aus der Vagina), die auf verschiedene Erreger getestet werden.
In vielen deutschen Großstädten gibt es darüber hinaus die Möglichkeit, sich anonym beraten und testen zu lassen, zum Beispiel bei AIDS-Hilfen oder in Gesundheitsämtern. Die Bundeszentrale für gesundheitlich Aufklärung hat außerdem eine Telefon- und Onlineberatung eingerichtet, wo du erste Informationen und Hilfe bei einem Verdacht auf STI einholen kannst.
Darüber zu reden, hilft Tabus zu brechen
Sexuell übertragbare Krankheiten sind Teil unseres Lebens. Sie verschwinden nicht, wenn wir sie verschweigen und verheimlichen, sollten wir darunter leiden. STI sind heute gut behandelbar, doch sollte das kein Freibrief sein, sie aus unseren Überlegungen ausklammern. Darüber reden hilft, das Tabu zu brechen und schützt damit nicht nur uns selbst, sondern auch die Menschen, die wir lieben.
Mehr über die #weltverbesserer erfahren
Mehr #weltverbessern:
- Frauengesundheit und Männergesundheit: Unterschiede und Gemeinsamkeiten
- Reden hilft! Ein Gespräch über Suizid und warum man darüber sprechen sollte
- Beziehungen: Monogam, polygam oder LAT? Die Zukunft der Partnerschaft
Bitte lies unseren Hinweis zu Gesundheitsthemen.
** mit ** markierte oder orange unterstrichene Links zu Bezugsquellen sind teilweise Partner-Links: Wenn ihr hier kauft, unterstützt ihr aktiv Utopia.de, denn wir erhalten dann einen kleinen Teil vom Verkaufserlös. Mehr Infos.
















